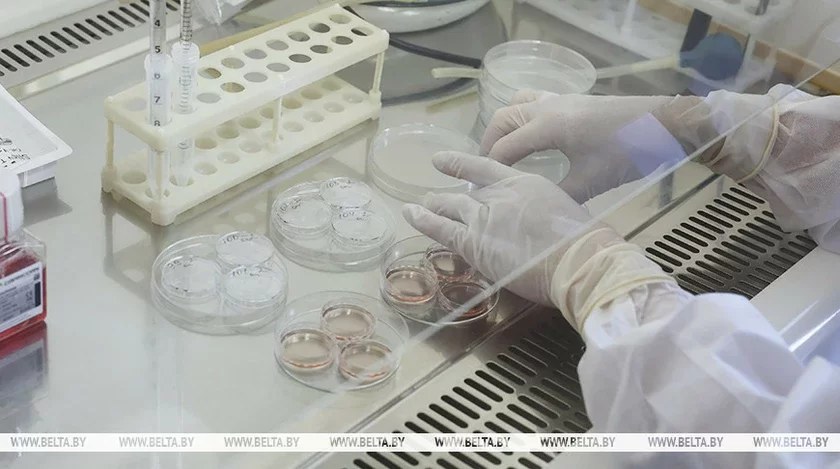

Вторую бесплатную попытку ЭКО могут начать предоставлять в Беларуси с 2026 года
В Беларуси с 2026 года могут начать предоставлять вторую бесплатную попытку экстракорпорального оплодотворения. Об этом сообщил начальник отдела медицинской помощи матерям и детям Министерства здравоохранения Дмитрий Лазарь, пишет БелТА.
Врач отметил, что ЭКО на бюджетной основе — очень востребованная мера поддержки.
«В настоящее время рассматривается вопрос о том, что вторая попытка экстракорпорального оплодотворения тоже будет предоставляться бесплатно. Я думаю, это станет возможным в следующем, 2026 году. Сейчас вносятся изменения в законодательство, просчитывается материальная нагрузка. После окончания этих процессов процедура будет запущена», — рассказал Дмитрий Лазарь.
Всего за четыре года действия программы бесплатной попытки ЭКО потрачено около 22 млн рублей.
За это время проведено 6095 циклов экстракорпорального оплодотворения, и наступили 2424 клинические беременности.
Сейчас читают
«Почему я должен доказывать, что не тунеядец?» Предпринимателя из Гомеля ошибочно записали в незанятые — он узнал только после огромных счетов за коммуналку












































Комментарии